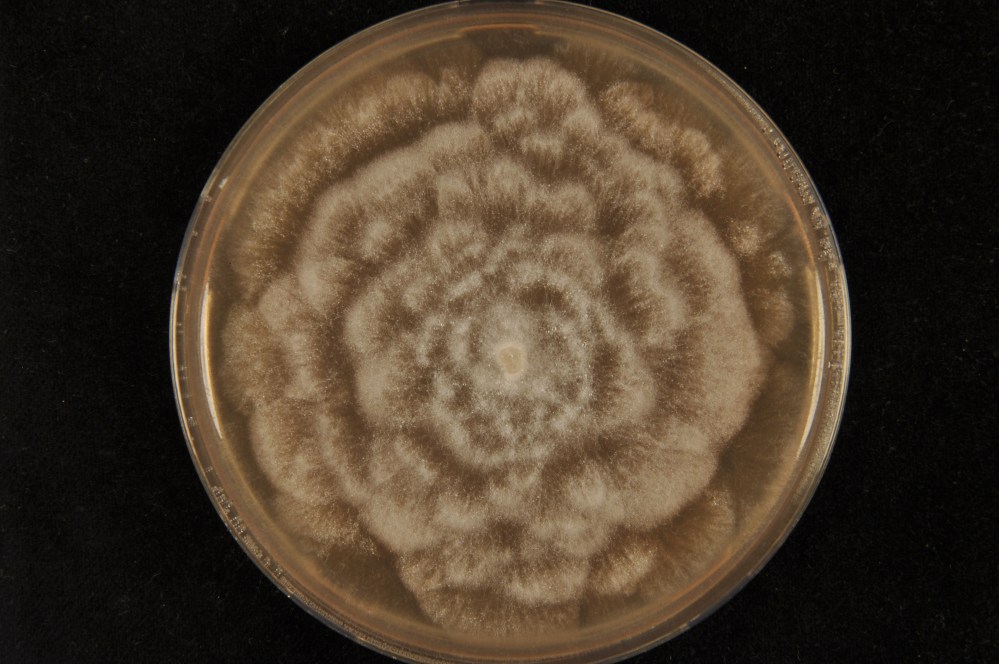
Halophytophthora sp. Kers (c) Johan Meffert

Waterschimmel hindert zeegrasherstel
Onder deze of een soortgelijke titel verscheen afgelopen week het zeegrasonderzoek uitgebreid in de media. Reden was het uitkomen van een nieuwe wetenschappelijke publicatie in het gerenommeerde wetenschappelijke tijdschrift Proceedings of the Royal Society B dat via deze link bekeken kan worden.
Dit onderzoek is genoemd op onder andere NU.nl, NatureToday.com, Waddenvereniging.nl, Vroege Vogels Radio, BNR nieuwsradio, Omrop Fryslan en enkele dagbladen (NRC, Dagblad van het Noorden, Leeuwarder Courant).
Verwant aardappelziekte bedreigt herstel van zeegrassen
Nederlandse onderzoekers hebben ontdekt dat de aan de bekende aardappelziekte verwante waterschimmels – Phytophthora gemini en Halophytophthora sp. Zostera – de zaadkieming van zeegras belemmeren. Dat kwam aan het licht tijdens herstelproeven in de Waddenzee en de Grevelingen. Uit vervolgonderzoek blijkt dat de ziekteverwekkers niet alleen in Nederland voorkomen, maar op veel meer locaties in Europa en Amerika. De aanwezigheid van deze waterschimmels bedreigt het herstel van zeegrasvelden wereldwijd, omdat veel herstelprojecten worden uitgevoerd met behulp van zaad.
Aardappelziekte
De meest bekende waterschimmel (Phytophthora infestans) is de aardappelziekte. Deze veroorzaakt jaarlijks voor miljarden euro’s schade aan de Europese landbouw. Verwante ziekteverwekkers zijn verantwoordelijk voor grote sterfte van eiken in California en eucalyptusbomen in Australië. In totaal zijn er ongeveer 100 verschillende ziekteverwekkers bekend uit deze familie. De meeste komen alleen op één of meerdere specifieke waardplanten voor: van aardbeien en tomaten, tot sojabonen en 50 meter hoge Nieuw-Zeelandse Kauri bomen. Hoewel planten zoals zeegras, mangroves en kwelderplanten de basis vormen van kustecosystemen wereldwijd, was er tot nu toe verrassend genoeg vrijwel niets bekend over Phytophthora-soorten in zeewater. Deze week publiceert een internationaal team onder leiding van Nederlandse onderzoekers (RU, RUG, NIOZ, NVWA, the Fieldwork Company, Virginia Institute of Marine Science) een studie dat het gevaar van dit type ziekteverwekkers laat zien voor zeegras. De studie verschijnt in het gerenommeerde tijdschrift Proceedings of the Royal Society B.
Besmette zeegraszaden
Het onderzoekersteam verzamelde zeegraszaad uit vijf Europese landen (Nederland, Duitsland, Denemarken, Zweden, Frankrijk) en uit Chesapeake Bay, Verenigde Staten. Zaad van al deze locaties bleek besmet te zijn door een Phytophthora-soort, of daaraan verwante Halophytophthora-soorten die tot nu toe slechts bekend waren als afbraakschimmels die dode plantenresten opruimen. Hoofonderzoeker Laura Govers (Radboud Universiteit & Rijksuniversiteit Groningen): “In een laboratoriumproef hebben we vervolgens de kiemkracht van besmette zaden getest, deze bleken 6x minder vaak te kiemen dan niet-besmet zaad: slechts 3-4% van alle besmette zaden kiemde”.
Zeegrasherstel
Wereldwijd zijn veel kustecosystemen, waaronder zeegrasvelden, de afgelopen decennia hard achteruitgegaan. In Nederland zijn de uitgestrekte zeegrasvelden die oorspronkelijk in de Waddenzee stonden na 1930 verdwenen en nooit meer teruggekomen. Deze velden droegen bij aan een hoge biodiversiteit doordat veel diersoorten in het zeegras leefden. De velden vormden een belangrijke kraamkamer voor vissoorten zoals haring. Ook droegen ze bij aan kustbescherming door de golfslag te dempen en maakten het water helderder. Net als op andere plaatsen waar het zeegras verloren ging, wordt in Nederland daarom onderzocht of zeegrasherstel in de Nederlandse Waddenzee mogelijk is. Sinds 2011 wordt hiervoor gebruik gemaakt van zeegraszaad op Sylt. Tegenvallende kieming was de aanleiding voor Natuurmonumenten en Rijkswaterstaat, de huidige trekkers van het zeegrasherstel, om nader onderzoek te financieren. Daaruit bleek dat bijna 100% van het zaad besmet is met Phytophthora. Nu bekend is dat besmette zaden zeer slecht kiemen, wordt gezocht naar een oplossing om besmetting te verminderen en de kansen voor zeegrasherstel te vergroten, bijvoorbeeld door zaden te behandelen tijdens opslag met een koperoplossing. Deze methode wordt ook al sinds de 19e eeuw in de landbouw tegen Phytophthora-besmetting ingezet en lijkt ook veelbelovend voor zeegraszaad.
Dit onderzoek is het resultaat van een samenwerking tussen Radboud Universiteit Nijmegen – Rijksuniversiteit Groningen – NVWA – NIOZ- the Fieldwork Company – Virginia Institute of Marine Science en werd gefinancierd door Natuurmonumenten, Rijkswaterstaat en de Nederlandse Voedsel en Waren Autoriteit (NVWA).
Foto van een waterschimmelkolonie (Halophytophthora sp. Zostera) op kersenagar. Deze waterschimmel is geisoleerd uit zeegraszaad



